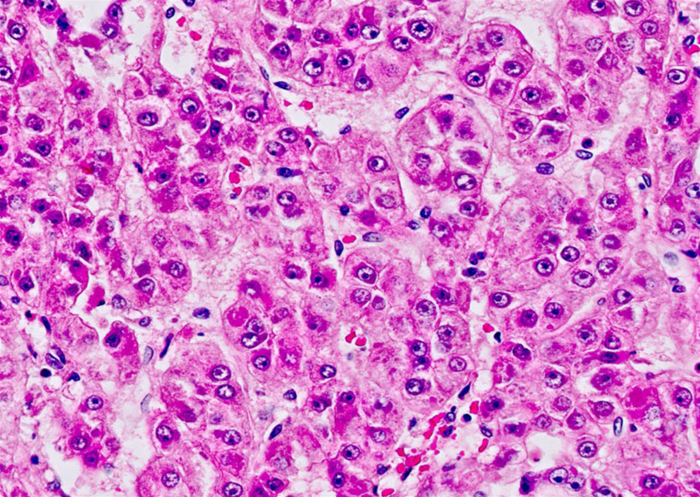
A 58-year-old man with a history of chronic liver disease secondary to hepatitis C infection comes to the office due to progressive fatigue and abdominal discomfort.  He has no other medical conditions, and a recent colonoscopy was normal.  Physical examination shows ascites and jaundice.  Ultrasonography of the abdomen reveals a solid mass within the liver parenchyma.  Surgical resection of the liver lesion is performed.  Microscopy reveals large cells with prominent nucleoli arranged in thickened plates as shown below.   Which of the following serum markers would be most useful for monitoring this patient for disease recurrence? A) 5-Hydroxyindoleacetic acid B) Alpha-fetoprotein C) CA 125 D) CA 19-9 E) Carcinoembryonic antigen F) Human chorionic gonadotropin

A 58-year-old man with a history of chronic liver disease secondary to hepatitis C infection comes to the office due to progressive fatigue and abdominal discomfort. He has no other medical conditions, and a recent colonoscopy was normal. Physical examination shows ascites and jaundice. Ultrasonography of the abdomen reveals a solid mass within the liver parenchyma. Surgical resection of the liver lesion is performed. Microscopy reveals large cells with prominent nucleoli arranged in thickened plates as shown below. Which of the following serum markers would be most useful for monitoring this patient for disease recurrence?
Which of the following serum markers would be most useful for monitoring this patient for disease recurrence?
A) 5-Hydroxyindoleacetic acid
B) Alpha-fetoprotein
C) CA 125
D) CA 19-9
E) Carcinoembryonic antigen
F) Human chorionic gonadotropin
Correct Answer:
Verified
Q287: A 53-year-old man with nocturnal cough undergoes
Q288: A 54-year-old man is evaluated in the
Q289: A 45-year-old woman comes to the office
Q290: A 3-week-old male born to a 23-year-old
Q291: A 34-year-old man is evaluated for elevated
Q293: A 43-year-old man is evaluated in the
Q294: A 31-year-old woman comes to the emergency
Q295: A 32-year-old man comes to the office
Q296: A 28-year-old man with vague abdominal pain,
Q297: A mass resected from the liver of
Unlock this Answer For Free Now!
View this answer and more for free by performing one of the following actions

Scan the QR code to install the App and get 2 free unlocks

Unlock quizzes for free by uploading documents